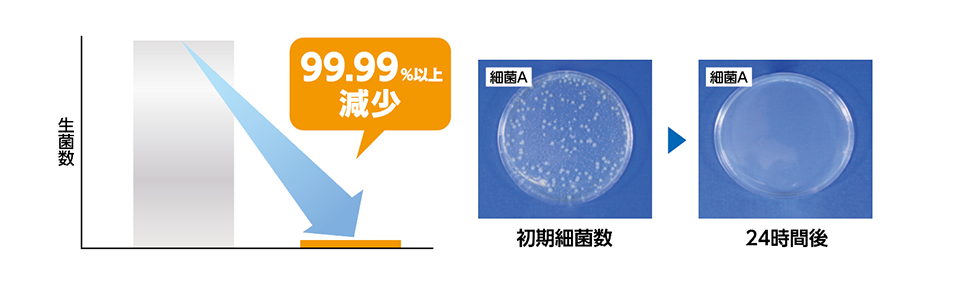

GIGAスクール構想の対応端末に最適な液晶画面保護フィルムは何かについて、迷われている方も多いかと思います。
GIGAスクール構想により、2023年度までに児童・生徒1人につき1台の端末環境、及び高速大容量の校内LANネットワークが整備されます。
生徒がタブレット等の端末を使用する際に、画面を傷つけてしまったり、端末を落下させてしまったりと、思わぬ事故による破損のリスクが高まります。
また、液晶画面を長時間見続けることによる子どもたちの視力低下や、疲れ目対策、眼病なども懸念されています。
そんな不安を、液晶保護フィルムが解消します!
液晶保護フィルムをつけることで液晶画面の傷や破損のリスクを大幅に軽減できるだけでなく、衛生面や安全性の向上、子どもたちの心身を守ることにもつながります。
この記事では「GIGAスクール構想の対応端末に最適な液晶画面保護フィルムとは?」と題して、GIGAスクール構想における液晶画面保護フィルムの必要性や、おすすめのフィルムについてなどをご紹介します。
GIGAスクール構想における保護フィルムの重要性
液晶保護フィルムの効果
- iPadや端末の液晶画面の損壊リスクを軽減
- ブルーライトカット効果により、目の疲れや身体への悪影響を軽減
- 1時間で99%以上のウイルスを除去する超抗菌効果
- のぞき見防止効果によりプライバシーを保護
- ペーパーライクフィルムによりタッチペンの書き心地を向上
- 指紋がつきにくく、ついたとしても拭き取りやすい
iPadや端末の液晶画面の損壊リスクを軽減
液晶保護フィルムをつけた状態でiPadを落下した場合、液晶保護フィルムにヒビが入ることはあっても、よほどの高さから落下したり衝撃を与えない限りはipad本体の液晶画面が損傷するリスクは極めて低くなります。
液晶保護フィルムつけていない状態でipadを落下した場合、ダイレクトに液晶画面に衝撃が加わるため、損傷する確率は大幅にアップしてしまいます。
ipadの液晶画面を壊してしまった場合の修理費用
iPadの液晶画面を落下で壊してしまった場合、AppleCareの保証の対象外となるため、修理費用は全額自己負担となってしまいます。
機種にもよりますが1台につきおよそ2~4万円ほどの修理費用がかかってしまい、経済的な損失も大きなものとなってしまいます。
液晶保護フィルムを使うことによって、iPadや端末などの液晶画面の損壊リスクを大幅に軽減することができます。
子どもの心のケアにも
小中学生などのIT機器を使い慣れていない年齢の子どもたちほど、不注意によりデバイスを損傷しがちです。
デバイスを壊してしまった場合、多くの子どもたちが何らかの精神的な負担を感じてしまいます。
そうした事故を可能な限り防ぐためにも、液晶保護フィルムは重要です。
液晶保護フィルムをつけることは、液晶画面だけでなく、子どもたちの心の負担を軽減することにもつながります。
ブルーライトカット効果により、目の疲れや身体への悪影響を軽減

液晶画面から発せられるブルーライトにより、目の疲れ、睡眠の質の低下、自律神経への悪影響などの症状が報告されています。
液晶保護フィルムの「ブルーライトカット」機能により、それらの人体への悪影響を防止することができます。
ブルーライトとは
ブルーライトとは 波長が380から495ナノメートル前後の青色光のことをいいます。
人間の目で見ることのできる光=可視光線の中でも最も波長が短く強いエネルギーを持っており、角膜や水晶体で吸収されずに網膜まで到達します。
LED の普及に伴い顕著になった眼精疲労は、 LED に多量に含まれるブルーライトが非常に大きな原因になっていると指摘されています。
1時間で99%以上のウイルスを除去する抗菌効果|GIGAスクール構想 液晶画面保護フィルム

液晶保護フィルムのウイルス抗菌効果により、1時間で99%以上のウイルスを除去することが可能です。
新型コロナウイルス対策にも気を配る必要のあるご時世ですので、ウイルス対策ができる機能は、衛生面でも大きな安心につながります。
のぞき見防止効果によりプライバシーを保護
のぞき見防止効果により、周りから画面を覗きにくくすることができます。
個人情報保護の観点からも、情報漏洩をできるだけ防止することにつながります。
ペーパーライクフィルムによりタッチペンの書き心地を向上
iPadなどのタブレットを利用する場合、タッチペンを利用する教育機関様もいらっしゃいます。
タッチペンを使用する場合、書き心地が重要になってきます。
保護フィルムを何もつけない状態でタッチペンを利用すると、ペン先が滑りやすく書きづらいと感じる場合があります。
タッチペンが使いづらいとそれだけで集中力が削がれてしまうことも。
モバイルマートのペーパーライクフィルム機能により、まるで紙に書いたような書き心地を実現することによって、集中力アップも期待できます。
指紋がつきにくく、ついたとしても拭き取りやすい

iPadなどタブレットの液晶画面は指で触れることが多いので、指紋がついて残りやすくなってしまいます。
モバイルマートの液晶保護フィルムは、優れた耐指紋性を持っており指紋がつきにくい構造になっています。
また、指紋がついても見えにくく、かんたんに拭き取ることができます。
GIGAスクール構想で必要な保護フィルムの種類
学校のICT環境において、保護フィルムが使われている場所は端末以外にもいろいろあります。
液晶保護フィルムが使われている場所
- ipad・タブレット
- パソコンのモニター
- テレビ画面
- 校内LANの画面
- 学校用グッズの画面
- コピー機の操作画面
などをはじめ、すべての機器の液晶保護フィルムをご提供しています。
液晶画面は頻繁に指で触れるものも多いため、衛生面の管理が重要になってきます。
モバイルマートのフィルムは、抗ウイルス性、抗菌性両方のSIAAマークを取得しており、フィルムに含まれる銅イオンの力で、フィルムに付着したウイルスの数を99.99%減少させる力を発揮します。
液晶保護フィルム以外のフィルムも充実

モバイルマートでは液晶画面の保護フィルムだけでなく、多種多様な用途のフィルムをご用意しています。
- 背面用フィルム
- トラックパッド用フィルム
- パームレスト用フィルム
- 天板用フィルム
GIGAスクール構想において、例えば背面フィルムに学年やクラスや機器の管理番号などがわかるように、予め文字などを印刷して貼っておくことで管理をしやすく工夫されている教育機関様もいらっしゃいます。
GIGAスクール構想で生徒が利用する端末は?

GIGAスクール構想で生徒が使用する端末は、
- iPad
- Chrome book
- Windows PC
などがメインになっています。
すべての機器、機種の液晶保護フィルムのご注文を承っております。
モバイルマートのフィルムはすべて自社生産となっているため、お客様のご要望に柔軟にご対応致します。
まずはお客様の現在のご状況をお伺いし、15種類以上あるフィルムの中から最適なフィルムをご提案差し上げます。お気軽にお問合せください。
コメント